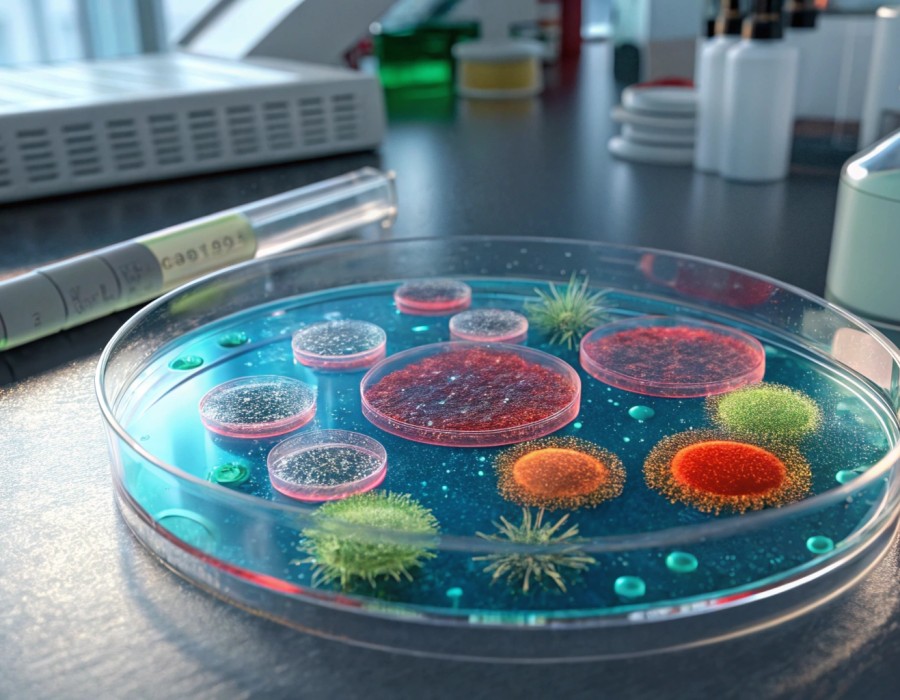

Japan 3D Cell Culture Market Size and Growth Overview (2026-2034)
Market Size in 2025: USD 174.3 Million
Market Forecast in 2034: USD 565.4 Million
Market Growth Rate 2026-2034: 13.97%
According to IMARC Group's latest research publication, "Japan 3D Cell Culture Market: Industry Trends, Share, Size, Growth, Opportunity and Forecast 2026-2034," the Japan 3D cell culture market size reached USD 174.3 Million in 2025. Looking forward, IMARC Group expects the market to reach USD 565.4 Million by 2034, exhibiting a growth rate (CAGR) of 13.97% during 2026-2034.
Request the Report Sample (2026 Edition): https://www.imarcgroup.com/japan-3d-cell-culture-market/requestsample
How AI is Reshaping the Future of the Japan 3D Cell Culture Market?
Artificial intelligence (AI) is dramatically changing the 3D cell culture market in Japan by helping to quicken research timelines, improve the accuracy of experiments, and open up new areas of drug discovery and regenerative medicine. AI-driven image analysis tools are changing the way researchers keep track of and study 3D cell cultures, as they accurately recognize morphological changes, cell viability, and tissue formation patterns that human researchers would find difficult, or even impossible, to detect on a consistent basis. Machine learning algorithms are playing culture condition optimization roles with the help of large datasets to establish ideal parameters for various cell types, growth factors, and scaffold materials.
Deep learning models are determining drug responses in 3D tissue models at levels that were never before possible; thus, traditional drug screenings that are time-consuming and expensive are being performed only for a few of the drugs. With the help of AI, the development of highly complex organ-on-a-chip technologies is now possible through the combination of sensor data and the generation of dynamic models that simulate physiological conditions even more accurately. Not only can these smart systems change culture parameters in real-time, but they can also keep 3D cultures under their best conditions for a longer time as well.
In the case of regenerative medicine, the use of AI extends to bioprinting tissue design by playing a role in optimizing scaffold architecture and the distribution of cells in patterns that will result in the maximum functionality and integration potential. Natural language processing is helping knowledge acquisition by going through scientific literature and locating potential applications, protocols, and strategies for optimization. As Japan continues to be a leader in precision medicine and a source of biotechnological innovations, AI-driven 3D cell culture platforms are concertedly putting the country in the forefront of next-generation drug discovery, personalized medicine, as well as tissue engineering breakthroughs.
Japan 3D Cell Culture Market Trends & Drivers
Artificial intelligence (AI) is completely revolutionizing the Japan 3D cell culture market to shorten research timelines, to perform experiments of a higher quality, and to lead new paths in drug discovery and regenerative medicine. Researchers are no longer taking a back seat, while AI-driven image analysis tools, which revolutionize the way research is done, are advancing the study of and monitoring of the 3D cell cultures to accurately detect morphological changes, cell viability, and tissue formation patterns that a human researcher would hardly, or even be unable, to carry out on a time-uniform basis. Machine learning algorithms are culture condition optimizers with the help of extensive datasets for setting optimum parameters for various cell types, growth factors, and scaffold materials.
Deep learning models are identifying drug responses at levels that were never anticipated in 3D tissue models, and so traditional drug screenings that take up a lot of time and are costly are only being carried out for a few of the drugs. AI has allowed the creation of highly complex organ-on-a-chip technologies by integrating sensor data and generating dynamic models that depict physiological conditions with even greater accuracy. These intelligent devices are not only able to change culture parameters in real-time, but they can also keep 3D cultures under the best conditions for a longer time.
In regenerative medicine, the use of AI in bioprinting tissue design is extending with a role in scaffold architecture optimization and distribution of cells in patterns that will result in maximum functionality and integration potential. NLP is assisting knowledge acquisition by digesting scientific literature and locating applications, protocols, and strategies for optimization. While Japan continues to be a leader in precision medicine and a source of biotechnological innovations, AI-powered 3D cell culture platforms are the means by which the country is being concertedly positioned at the forefront of next-generation drug discovery, personalized medicine, and tissue engineering breakthroughs.
Japan 3D Cell Culture Industry Segmentation:
The report has segmented the market into the following categories:
Product Insights:
- Scaffold-Based Platforms
- Scaffold-Free Platforms
- Microchips
- Bioreactors
- Others
Application Insights:
- Cancer Research
- Stem Cell Research
- Drug Discovery
- Regenerative Medicine
- Others
End User Insights:
- Biotechnology and Pharmaceutical Companies
- Contract Research Laboratories
- Academic Institutes
- Others
Regional Insights:
- Kanto Region
- Kansai/Kinki Region
- Central/ Chubu Region
- Kyushu-Okinawa Region
- Tohoku Region
- Chugoku Region
- Hokkaido Region
- Shikoku Region
Request a Customized Version of This Report for Deeper Insights: https://www.imarcgroup.com/request?type=report&id=19369&flag=E
Competitive Landscape:
The market research report offers an in-depth analysis of the competitive landscape, covering market structure, key player positioning, top winning strategies, a competitive dashboard, and a company evaluation quadrant. Additionally, detailed profiles of all major companies are included.
Recent News and Developments in Japan 3D Cell Culture Market
October 2024: Leading Japanese research institutions announced breakthrough developments in organoid technology, creating more complex and functional 3D tissue models for disease modeling and drug screening applications.
November 2024: Major biotechnology companies in Japan launched advanced scaffold-based platforms with improved biocompatibility and structural integrity, enabling longer-term culture of complex tissue structures for regenerative medicine research.
December 2024: Japanese pharmaceutical companies expanded their adoption of 3D cell culture systems in drug development pipelines, reporting significant reductions in development timelines and improved prediction of clinical outcomes compared to traditional 2D models.
Future Outlook
The future of Japan's 3D cell culture market is exceptionally promising, with accelerated growth anticipated through 2034. As precision medicine and personalized therapy become mainstream, demand for patient-specific 3D tissue models will surge. Integration with bioprinting technologies, microfluidics, and organ-on-a-chip systems will enable creation of increasingly sophisticated physiological models. The convergence of 3D cell culture with artificial intelligence and high-throughput screening will revolutionize drug discovery, reducing development costs and timelines. Japan's continued investment in regenerative medicine and tissue engineering will position 3D cell culture as an indispensable technology for advancing healthcare innovation and improving patient outcomes.
Key highlights of the Report:
- Market Performance (2020-2025)
- Market Outlook (2026-2034)
- COVID-19 Impact on the Market
- Porter's Five Forces Analysis
- Strategic Recommendations
- Historical, Current and Future Market Trends
- Market Drivers and Success Factors
- SWOT Analysis
- Structure of the Market
- Value Chain Analysis
- Comprehensive Mapping of the Competitive Landscape
Note: If you require specific details, data, or insights that are not currently included in the scope of this report, we are happy to accommodate your request. As part of our customization service, we will gather and provide the additional information you need, tailored to your specific requirements. Please let us know your exact needs, and we will ensure the report is updated accordingly to meet your expectations.
About Us:
IMARC Group is a global management consulting firm that helps the world's most ambitious changemakers to create a lasting impact. The company provides a comprehensive suite of market entry and expansion services. IMARC offerings include thorough market assessment, feasibility studies, company incorporation assistance, factory setup support, regulatory approvals and licensing navigation, branding, marketing and sales strategies, competitive landscape and benchmarking analyses, pricing and cost research, and procurement research.
Contact Us:
Street: 563-13 Kamien
Area: Iwata
Country: Tokyo, Japan
Postal Code: 4380111
Email: [email protected]

Comments